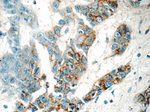
GJB3 Antibody in Immunohistochemistry (Paraffin) (IHC (P))

Search
Proteintech
GJB3 Polyclonal Antibody
{{$productOrderCtrl.translations['antibody.pdp.commerceCard.promotion.promotions']}}
{{$productOrderCtrl.translations['antibody.pdp.commerceCard.promotion.viewpromo']}}
{{$productOrderCtrl.translations['antibody.pdp.commerceCard.promotion.promocode']}}: {{promo.promoCode}} {{promo.promoTitle}} {{promo.promoDescription}}. {{$productOrderCtrl.translations['antibody.pdp.commerceCard.promotion.learnmore']}}

Please note: We are reviewing Western blot images included in the antibody testing data in our catalog, including those provided by third parties. Unless expressly labeled or annotated as “raw-unedited”, Western blot images included in the antibody testing data in our catalog may have been edited, optimized or otherwise adjusted for presentation.
产品信息
12880-1-AP
种属反应
已发表种属
宿主/亚型
分类
类型
抗原
偶联物
形式
浓度
规格
纯化类型
保存液
内含物
保存条件
运输条件
产品详细信息
Immunogen sequence: RERRHRQKH GDQCAKLYDN AGKKHGGLWW TYLFSLIFKL IIEFLFLYLL HTLWHGFNMP RLVQCANVAP CPNIVDCYIA RPTEKKIFTY FMVGASAVCI VLTICELCYL ICHRVLRGLH KDKPRGGCSP SSSASRASTC RCHHKLVEAG EVDPDPGNNK LQASAPNLTP I (101-270 aa encoded by BC012918)
靶标信息
Gap junctions are conduits that allow the direct cell-to-cell passage of small cytoplasmic molecules, including ions, metabolic intermediates, and second messengers, and thereby mediate intercellular metabolic and electrical communication. Gap junction channels consist of connexin protein subunits, which are encoded by a multigene family. GJBs (gap-junction proteins or connexins) play crucial functional roles associated with these channels. Defects in GJB3 have been linked to erythrokeratodermia variabilis (EKV) is an autosomal dominant genodermatosis characterized by transient figurate red patches or hyperkeratosis. Mutations in GJB2 have also been associated with genetically derived hearing impairments, including autosomal recessive nonsyndromic deafness.
仅用于科研。不用于诊断过程。未经明确授权不得转售。
生物信息学
蛋白别名: connexin 31; Connexin-31; Cx31; Gap junction beta-3 protein; gap junction membrane channel protein beta 3; gap junction protein, beta 3, 31kDa; unnamed protein product
基因别名: Cnx31; CX31; Cxn-31; D4Wsu144e; DFNA2; DFNA2B; EKV; EKVP1; Gjb-3; GJB3
UniProt ID: (Mouse) P28231, (Rat) P25305
Entrez Gene ID: (Human) 2707, (Mouse) 14620, (Rat) 29585




